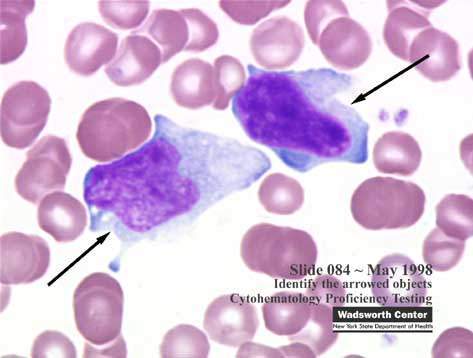
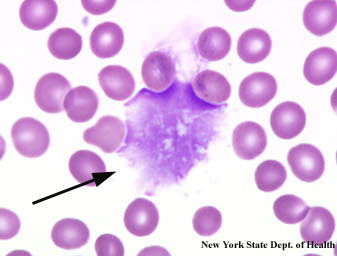

1
Q

A
Strep pneumo
2
Q

A
Giardia lamblia
3
Q

A
Sporothrix schenckii
4
Q

A
Toxoplasma gondii
5
Q

A
Actinomyces
6
Q

A
Nocardia
7
Q

A
candida albicans
8
Q

A
plasmodium vivax or ovale
9
Q

A
Naegleria fowleri
10
Q

A
Entamoeba histolytica
11
Q

A
Gardnerella vaginalis
12
Q

A
malassezia furfur
13
Q

A
syphilis
14
Q

A
cryptococcus neoformans
15
Q

A
Trichomonas vaginalis
16
Q

A
ehrlichiosis - rickettsial disease - morulae (berry-like inclusions) present in the cytoplasm of monocyte cytoplasm
17
Q

A
Trypanosoma brucei
18
Q
A
EBV - atypical T cells “downey cells”
do not confuse w/ smudge cells in CLL (see image)
19
Q

A
bacillus anthracsis
20
Q

A
blastomycosis - broad based buds
21
Q

A
neisseria - present in neutrophils
22
Q
acid fast stain of lung isolate

A
mycobacterium
23
Q

A
histoplasmsois - hides in macrophages
24
Q

A
mucormycosis and Rhizopus
25

Leishmania donovani
26

CMV - owl eye inclusions
27

paracoccidioidomycosis
28

pseudomonas - blue/green pigment
29

Staph aureus
30

corynebacterium diphtheriae
31

Pneumocystis jirovecii
32
acid fast stain from the GI

Cryptosporidium
33

Rabies - Negri body
34

coccidioidomycosis - spherules filled w/ endospores "coccidio crowds"
35

Aspergillus fumigatus
36

Trypanosoma cruzi
37

Babesia
38
Tzanck smear

Herpes
## Footnote
*Tzanck heavens I do not have herpes!*


